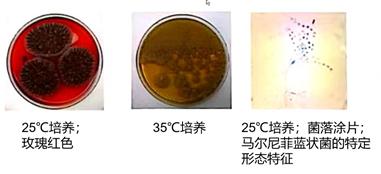
反复呼吸道感染病例分享,呼吸道感染鉴别诊断病例

患者病史
患者男性,21 岁,农民
患者主诉:反复发热、咳嗽咳痰超过3年
病史:高热,体温高达40℃、寒战,伴咳嗽、痰白和消瘦症状。左上臂有脓包,大小2.5×2cm。穿刺取脓液进行细菌培养,金黄色葡萄球菌呈阳性。由于患者可能为金黄色葡萄球菌感染,对患者依次使用抗感染药物“哌拉西林/他唑巴坦+左氧氟沙星”和“万古霉素+美罗培南”进行治疗。治疗期间,患者反复发热、咳嗽、咳痰,并有明显的颈部淋巴结肿大和肝脾肿大。
自述病史:18岁患有肺结核(痰培养出结核杆菌,TB-DNA检测阳性),接受标准治疗6个月后症状和影像学明显改善。
无吸烟、酗酒、家族特殊疾病遗传史。
检查诊断
1. 体格检查:
√ 体温(T)37.0℃,脉搏(P.)115次/分,呼吸频率(RR)22次/分,血压(BP)127/77mmHg,血氧饱和度(SpO2)98%(室内压)
√ 头脑清醒;颈部淋巴结肿大
√ 左上臂有2.5×2cm大小脓包,按压痛,无潮红,固定器中检测有起伏感
√ 两肺听诊呼吸音稍弱;无干、湿啰音
√ 肝脾肿大,肝脏叩诊无疼痛
2. 实验室检查
血常规检查——嗜酸性粒细胞显著增加

3. 病原学检查
病毒:HIV(-)、呼吸道病毒(-)、肝炎病毒(-)
结核:血T-SPOT(-)、抗酸杆菌多痰涂片(-)、痰TB-DNA(-)
细菌:多痰细菌培养(-)、PCT(+)
真菌:G试验>901.9pg/mL;GM试验(+)、曲霉抗原检测(+)、多痰真菌培养(-)
4. 影像学检查:胸CT扫描显示双肺双侧磨玻璃影,左上肺出现空腔

5. 进一步检查:
全身PET-CT扫描显示肝脏和脾脏肿大,脾脏肿大尤其明显,伴多发性全身淋巴结肿大,未见恶性肿瘤。骨髓活检显示仅骨髓嗜酸性粒细胞增多。骨髓FISH检测阴性[核原位杂交(PDGFRB×2);(PDGFRA×2);(FGFR1×2)]
6. 颈部淋巴结活检 :
√ 淋巴结中有众多上皮样肉芽肿,伴有众多多核巨细胞,少数肉芽肿呈中央干酪样坏死
√ PAS和六甲胺银染色证实多核巨细胞细胞质中存在大量真菌孢子
√ 耐酸色牢度阴性
√ 诊断:淋巴结真菌感染

7. 血和组织培养:马尔尼菲蓝状菌
8. 诊断结果:全身性马尔尼菲蓝状菌感染
治疗药物:伏立康唑 200mg q12h
随访与最终诊断
1. 随访 - 第 2 阶段病史:患者使用抗真菌药物伏立康唑治疗后,症状得到改善(退热、颈部淋巴结缩小);痰和血培养马尔尼菲蓝状菌检测呈阴性,影像学检查显示患者病情稳定,因此暂停药物治疗。2个月后患者因反复发热和头痛且再次出现颈部淋巴结肿大和肝脾肿大再次入院。
2. 讨论: 患者因何出现反复全身性马尔尼菲蓝状菌感染?
马尔尼菲蓝状菌感染的危险因素?
(1)HIV感染 ✘
(2)非HIV感染
➢抗IFN-γ-自身抗体 ✘
➢自身免疫疾病
➢器官移植 ✘
➢血液系统恶性肿瘤和抗肿瘤药物使用者 ✘
➢特发性CD4 + T细胞缺乏症 ✘
3. 进一步检查:HIV抗体试验和肿瘤指数测试均为阴性,患者T细胞亚群正常(CD4+和CD8+细胞比例分别为33.2%和30.4%),免疫球蛋白(IgA、IgG和IgM)数量正常,无恶性疾病。此外,患者IFN-γ蛋白和IFN-γ受体蛋白高于正常水平。

患者嗜酸性粒细胞明显升高(2017年2月,IgE总数量1159;2018年1月,IgE总数量683),患者是否为成人高IgE综合征?

4. Ad-HIES 诊断标准:
临床诊断:NIH临床诊断评分系统
- >30分(敏感性87.5%,特异性80.6%)
- >40分可临床诊断,20-40分需随访,<20分无法诊断
A疑似诊断:IgE>1000U/mL+NIH临床诊断评分系统>30分
B临床诊断:A+Th17表达↓/HIES诊断家族史
C确诊:B+STAT3突变
5. Ad-HIES 的诊断
√ 患者得分51分
√ 患者父亲和姐姐血清IgE表达水平升高,分别为378.14kU/L和>2000kU/L
√ 患者IL-17表达水平明显低于他弟弟
√ 患者、父亲和姐姐STAT3基因突变,595位点精氨酸向谷氨酰胺转变

6. 最终诊断:成人高IgE综合征合并复发性全身性马尔尼菲蓝状菌感染
由于针对成人高IgE综合征无较好的治疗方案,当前治疗主要针对马尔尼菲蓝状菌感染(伏立康唑200mg q12h)